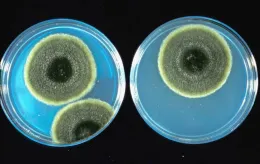
alt on media

Pomegranate (Punica granatum)is a specialty crop now grown on more than 10,000 acres. Pomegranate production has increased for both fresh market and juice in the last several years and black heart has become a disease of major concern to the growers. The absence of external symptoms makes the diagnosis of the disease very difficult, and consumers encountering the disease may change their perception of the pomegranate’s many health benefits. Therefore, it is essential to find ways to control the disease.